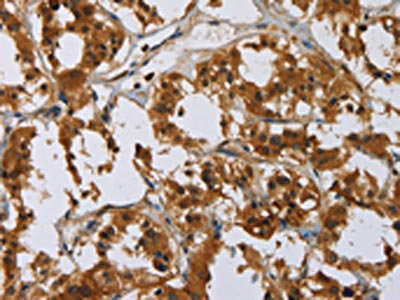

GATA5 Antibody
-
中文名稱:GATA5兔多克隆抗體
-
貨號(hào):CSB-PA944675
-
規(guī)格:¥1100
-
圖片:
-
The image on the left is immunohistochemistry of paraffin-embedded Human thyroid cancer tissue using CSB-PA944675(GATA5 Antibody) at dilution 1/50, on the right is treated with synthetic peptide. (Original magnification: ×200)
-
The image on the left is immunohistochemistry of paraffin-embedded Human brain tissue using CSB-PA944675(GATA5 Antibody) at dilution 1/50, on the right is treated with synthetic peptide. (Original magnification: ×200)
-
-
其他:
產(chǎn)品詳情
-
Uniprot No.:
-
基因名:GATA5
-
別名:GATA binding protein 5 antibody; GATA-binding factor 5 antibody; GATA5 antibody; GATA5_HUMAN antibody; Transcription factor GATA-5 antibody
-
宿主:Rabbit
-
反應(yīng)種屬:Human
-
免疫原:Synthetic peptide of Human GATA5
-
免疫原種屬:Homo sapiens (Human)
-
標(biāo)記方式:Non-conjugated
-
抗體亞型:IgG
-
純化方式:Antigen affinity purification
-
濃度:It differs from different batches. Please contact us to confirm it.
-
保存緩沖液:-20°C, pH7.4 PBS, 0.05% NaN3, 40% Glycerol
-
產(chǎn)品提供形式:Liquid
-
應(yīng)用范圍:ELISA,IHC
-
推薦稀釋比:
Application Recommended Dilution ELISA 1:2000-1:5000 IHC 1:50-1:200 -
Protocols:
-
儲(chǔ)存條件:Upon receipt, store at -20°C or -80°C. Avoid repeated freeze.
-
貨期:Basically, we can dispatch the products out in 1-3 working days after receiving your orders. Delivery time maybe differs from different purchasing way or location, please kindly consult your local distributors for specific delivery time.
-
用途:For Research Use Only. Not for use in diagnostic or therapeutic procedures.
相關(guān)產(chǎn)品
靶點(diǎn)詳情
-
功能:Transcription factor required during cardiovascular development. Plays an important role in the transcriptional program(s) that underlies smooth muscle cell diversity. Binds to the functionally important CEF-1 nuclear protein binding site in the cardiac-specific slow/cardiac troponin C transcriptional enhancer.
-
基因功能參考文獻(xiàn):
- findings show that GATA5 mutations, in addition to heart diseases, can result in congenital abnormalities of the female genitourinary tract in humans PMID: 28180938
- A multivariate regression model revealed that the effects of both the promoter methylation and the exonic SNPs in GATA5 were independent.This interaction between GATA5 variants and GATA5 promoter methylation indicates that the association of either factor with gastric disease progression is modified by the other PMID: 27225266
- These results suggest that the induction of GATA-6 dysfunction may be more effective for chemotherapy for colorectal cancer, although the mechanism underlying the synergistic effect of 5-FU and anisomycin remains unknown. PMID: 27404124
- The Correlation between GATA5, WT1 and PAX5 methylation and clinical/histological parameters is suggestive of applicability of these markers in non-invasive (epi)genetic testing in hepatocellular carcinoma (HCC). PMID: 27171388
- we identified gene promoter methylation signatures (WT1, MSH6, GATA5 and PAX5) that are strongly correlated to, and can have a predictive value for the clinical outcome of oral squamous cell carcinoma patients PMID: 27491556
- Evidence supporting a genetic basis includes the autosomal dominance of Bicuspid aortic valve inheritance patterns, and the identification of mutations in GATA binding protein 5 transcription factor. PMID: 26766164
- Transcriptomic analysis of human microvascular endothelial cells with GATA5 knockdown reveals that GATA5 affects several genes and pathways critical for endothelial function. PMID: 26617239
- This study firstly links GATA5 mutation to DCM, which provides novel insight into the molecular mechanisms of DCM, suggesting a potential molecular target for the prenatal prophylaxis and allele-specific treatment of DCM. PMID: 25543888
- Promoter hypermethylation is an important mechanism of the transcriptional inactivation of GATA5 in invasive ductal breast carcinoma. PMID: 25148870
- A combination of GATA5 and SFRP2 methylation could be promising as a marker for the detection and diagnosis of colorectal cancers and adenomas. PMID: 25759530
- A new potentially pathogenic variant in GATA5 contributes to the development of bicuspid aortic valve syndrome. PMID: 25449525
- DSVs in the GATA5 gene promoter may increase the susceptibility to the development of VSD as a risk factor. PMID: 25515806
- Rare sequence variants, p.Gln3Arg and p.Leu233Pro, in GATA5 are associated with human bicuspid aortic valve. PMID: 24796370
- study provides genetic evidence on the association of GATA5 loss-of-function mutations with enhanced susceptibility to bicuspid aortic valve (BAV), providing novel insight into the molecular mechanism involved in human BAV PMID: 24638895
- Results of this study showed an association of somatic GATA5 mutations with TOF, providing further insight into the underlying molecular mechanism of TOF. PMID: 24573614
- Epigenetic alterations in GATA family members may be associated with aggressive tumor phenotypes in renal cell cancer PMID: 24549248
- Reduced GATA5 mRNA levels are associated with a poor clinical outcome, indicating a possible role of GATA5 for the development of aggressive clear cell renal cell carcinoma. PMID: 24533449
- GATA5, possibly through upregulation of eNOS, plays a role in the development of aortic dilatation in patients with unicuspid and bicuspid aortic valves. PMID: 24766859
- GATA5 mutations were associated with congenital heart disease. PMID: 23031282
- The findings expand the spectrum of GATA5 mutations linked to atrial fibrillation and provide novel insights into the molecular mechanism involved in the pathogenesis of atrial fibrillation PMID: 23295592
- GATA5 protein mutataion is reposnsible for congenital ventriculoseptal defect. PMID: 22961344
- In the present study, two novel heterozygous mutations of GATA5, p.R187G and p.H207R, were identified in 2 families with TOF. In each family, the mutant allele was present in all the affected family members PMID: 23289003
- the prevalence and spectrum of GATA5 mutations in patients with familial atrial fibrillation PMID: 22483626
- A novel heterozygous GATA5 loss-of-function mutation of p.W200G identified in a family with lone atrial fibrillation is reported. PMID: 23175127
- Rare non-synonymous variations in the functionally important GATA5 transcriptional activation domains may be important in the pathogenesis of BAV disease in humans. PMID: 22641149
- USF1 transactivates GATA5 expression by binding to the E-box in its promoter PMID: 22625849
- Two new epigenetic subgroups of gastroesophageal adenocarcinomas were identified that differ to some extent in their survival rates, risk factors of exposure, and GATA5 DNA methylation. PMID: 22028801
- Epigenetic inactivation of GATA-5 by methylation of CpG islands is an early frequent event during gastric carcinogenesis and is significantly correlated with H. pylori infection. PMID: 20222162
- demonstrate that GATA-5 and HNF-1alpha physically associate both in vivo and in vitro and that this interaction is necessary for cooperative activation of the lactase-phlorizin hydrolase promoter PMID: 12011060
- in colorectal cancer and gastric cancer promoter hypermethylation and transcriptional silencing are frequent for GATA-4 and -5 PMID: 14612389
- Hypermethylation of the GATA5 is associated with lung cancer PMID: 15585625
- Methylation of GATA-5 was associated with ovarian carcinogenesis PMID: 16337738
- Frequent silencing of GATA-4 and GATA-5 in human esophageal neoplasia is associated with gene promoter hypermethylation. PMID: 16823849
- While hypermethylation of GATA-5 seems to be a universal feature among human tumors, infrequent methylation of GATA-4, and its corresponding overexpression, appears unique to pancreatic cancer from other tumor types reported thus far. PMID: 17912029
- Methylation of GATA4/5 is a common and specific event in colorectal carcinomas, and GATA4/5 exhibit tumor suppressive effects in colorectal cancer cells in vitro. GATA4 methylation in fecal DNA may be of interest for colorectal cancer detection. PMID: 19509152
顯示更多
收起更多
-
相關(guān)疾病:Tetralogy of Fallot (TOF)
-
亞細(xì)胞定位:Nucleus.
-
數(shù)據(jù)庫鏈接:
Most popular with customers
-
-
Phospho-YAP1 (S127) Recombinant Monoclonal Antibody
Applications: ELISA, WB, IHC
Species Reactivity: Human
-
-
-
-
-
-